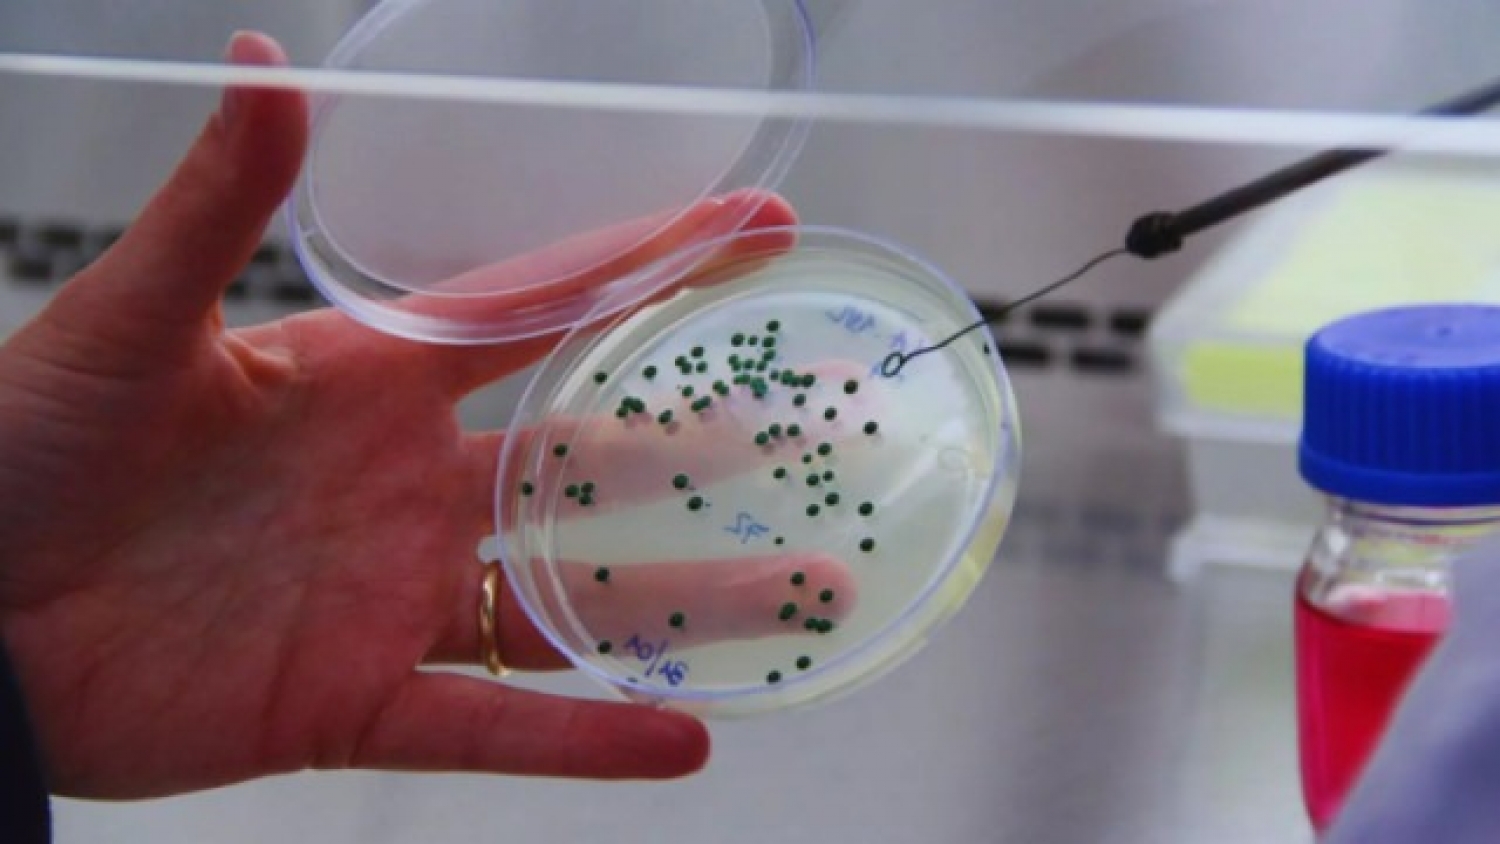
La levadura mendocina que potencia al Malbec y gana terreno en los mercados globales

En apenas cinco años, la levadura enológica Lalvin Tango, creada por especialistas del INTA, logró duplicar sus exportaciones: pasó de 833 kilos en 2018 a 1935 kilos en 2023. Este hito confirma el interés internacional por una cepa argentina de Saccharomyces cerevisiae seleccionada en los viñedos del INTA La Consulta (Mendoza), hoy presente en más de 14 países, entre ellos Estados Unidos, Francia, Italia, Alemania, Austria, España y Portugal.
La investigadora Mariana Combina, referente del Laboratorio de Microbiología Enológica del INTA Mendoza e integrante del Conicet, recuerda el origen del proyecto:
“Cuando definimos al Malbec como vino emblema, vimos que las levaduras que usábamos eran importadas. Eso hacía que perdiéramos características únicas del Malbec argentino.”
Desde esa premisa se inició la búsqueda de una levadura capaz de resaltar aromas a frutos rojos, mantener acidez equilibrada y sumar untuosidad. Así nació Tango, una cepa pensada para preservar el sello sensorial del Malbec.
El proceso de selección exigió años de ensayos en bodega y evaluaciones fermentativas. La cepa elegida mostró un desempeño notable para reforzar el perfil frutal y el equilibrio en boca. Posteriormente, la levadura fue transferida a una empresa multinacional encargada de su producción y comercialización a escala global.
Para Combina, el impacto es doble: “Nos enorgullece que se use en tantos países. Pero también soñamos con que exista una industria nacional que la produzca para agregar valor en origen y beneficiar a los productores locales.”
El éxito de Tango abrió paso a un desafío mayor: estudiar y seleccionar levaduras autóctonas que habitan de forma natural en los viñedos argentinos. Cada una de estas cepas —explica Combina— imprime una huella sensorial única y puede ser clave para varietales como Bonarda o para las criollas, históricas y representativas de la vitivinicultura local.
Desde hace más de una década, el INTA trabaja en la recuperación de variedades criollas como Torrontés Riojano, Criolla Grande, Cereza y Moscatel Rosado, junto con sus levaduras asociadas. En la bodega experimental del instituto ya se producen vinos piloto que demuestran cómo estos microorganismos aportan aromas propios, complejidad y nuevos estilos.
Además, los equipos avanzan en el uso de consorcios microbianos —Saccharomyces y no Saccharomyces—, lo que permite reproducir la diversidad natural de los viñedos y obtener vinos más expresivos. Todas las levaduras aisladas se preservan en la Colección de Microorganismos de INTA Mendoza (CoMIM), un banco oficial con estándares internacionales para resguardar el patrimonio genético.
Para Combina, cada desarrollo es parte de un modelo de innovación que vincula territorio, ciencia e identidad:
“Cada levadura cuenta una historia: la del suelo, el clima, la planta y la gente que trabaja en el viñedo.”
Con Tango abriendo mercados y múltiples investigaciones en marcha, el INTA consolida su aporte a una vitivinicultura argentina con carácter propio y reconocimiento internacional.
